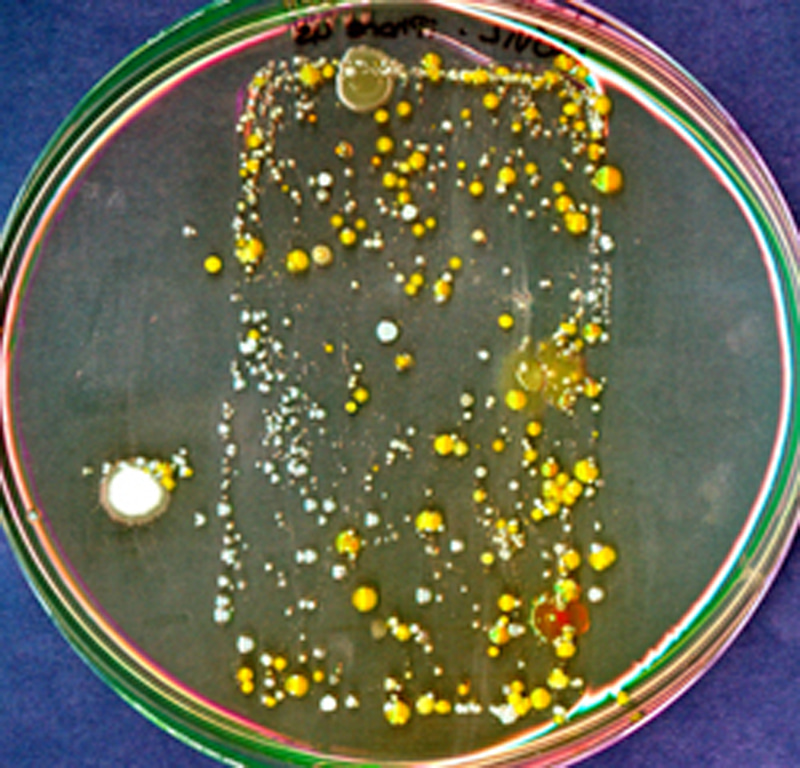

Like
Be the first to like this
Follow the Topic
Microbiology
Life Sciences > Biological Sciences > Microbiology
Please sign in or register for FREE
If you are a registered user on Research Communities by Springer Nature, please sign in